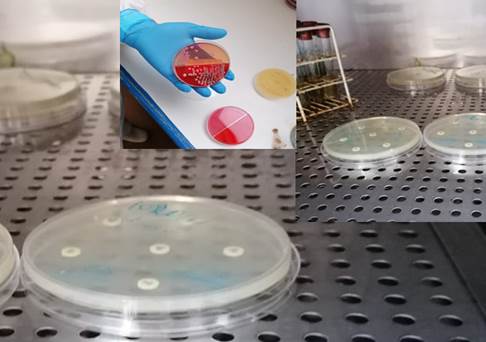
Imagen que contiene interior, tabla, utensilios de cocina, taza

Descripción generada automáticamente

http://dx.doi.org/10.35381/s.v.v5i1.1589
Interacción experimental de Escherichia Coli en óxido de grafeno aplicando propiedades de reducción grupo-funcional antibacteriana
Experimental interaction of Escherichia Coli on graphene oxide applying antibacterial group-functional reduction properties
Universidad Regional Autónoma de los Andes, Ambato
Ecuador
https://orcid.org/0000-0002-2463-7036
Ricardo Fabián Siza-Gualpa
Universidad Regional Autónoma de los Andes, Ambato
Ecuador
https://orcid.org/0000-0002-3775-4397
Recepción: 10 de agosto 2021
Revisado: 15 de septiembre 2021
Aprobación: 15 de noviembre 2021
Publicación: 01 de diciembre 2021
RESUMEN
Objetivo: determinar una ecuación que omita el paso de la experimentación y verifique la interacción de la bacteria GRAM NEGATIVA (Escherichia Coli) con el óxido de grafeno (GO), evaluando sus propiedades bactericidas al tener configuradas sus estructuras moleculares. Método: Cuasi experimental. Resultados: El óxido de grafeno es un material prometedor para aplicaciones biomédicas ya que al funcionalizarse puede dirigirse a las células donde debe ejercer su acción, además de eliminarse de manera rápida en el organismo. Las propiedades biológicas de los derivados de grafeno aún no son examinaron a fondo, por lo tanto, su citotoxicidad debe estudiarse en profundidad. Conclusión: El óxido de grafeno genera mejores resultados al tener un disco de sensibilidad de bacteria con buen proceso de aislamiento.
Descriptores: Escherichia coli; Proteínas de Escherichia coli; Experimento de Laboratorio. (Fuente: DeCS).
ABSTRACT
Objective: to determine an equation that omits the experimental step and verifies the interaction of GRAM NEGATIVE bacteria (Escherichia Coli) with graphene oxide (GO), evaluating its bactericidal properties by having its molecular structures configured. Method: Quasi-experimental. Results: Graphene oxide is a promising material for biomedical applications since when functionalized it can be directed to the cells where it should exert its action, besides being eliminated quickly in the organism. The biological properties of graphene derivatives have not yet been thoroughly examined, therefore, their cytotoxicity should be studied in depth. Conclusion: Graphene oxide generates better results by having a bacterial sensitivity disk with good isolation process.
Descriptors: Escherichia coli; Escherichia coli Proteins; Laboratory Experiment. (Source: DeCS).
INTRODUCCIÓN
La evaluación de las propiedades antibacterianas del óxido de grafeno se basa en cultivos celulares estáticos in vitro realizados con placas de pocillos múltiples (macroescala) (1) (2). Este tipo de cultivo celular se caracteriza por un crecimiento celular bidimensional (2D) (monocapa). Las células cultivadas como una monocapa sobre un sustrato sintético en condiciones estáticas no imitan el entorno celular natural. Además, la morfología y las rutas metabólicas de las células cultivadas in vitro difieren de las que se presentan en las células del cuerpo humano (3) (4) (5).
Ante esta necesidad, el presente trabajo de investigación tiene por objetivo determinar una ecuación que omita el paso de la experimentación y verifique la interacción de la bacteria GRAM NEGATIVA (Escherichia Coli) con el óxido de grafeno (GO), evaluando sus propiedades bactericidas al tener configuradas sus estructuras moleculares.
MATERIALES Y METODOS
Materiales
Se adquirió polvo de grafito con un tamaño de partícula <20 µm y trifenilfosfina (PPh3,) de Sigma-Aldrich. Todos los reactivos químicos necesarios para la preparación de GO. Adquirido en el departamento de nanotecnología YACHAY TECH.
Material de Laboratorio para antibiograma del Hospital IESS Latacunga – Ecuador.
Síntesis de ecuaciones utilizando Dinámica de Partículas.
Métodos
La investigación es de tipo cuasi experimental (6), basada en el estudio de las características de la membrana de una bacteria GRAM negativa junto a modelos matemáticos y espectroscópicos que describen las propiedades antibacteriales del grafeno. Tras la reducción del grupo funcional de la estructura del grafeno se demuestra el comportamiento antibacteriano de forma experimental. En base a los resultados obtenidos, se afirma que el comportamiento es eficaz para un sin número de bacterias ya sean gran positivos o negativas.
Síntesis de óxido de grafeno (GO)
GO se sintetizó a partir de polvo de grafito utilizando el enfoque de Hummers con una ligera modificación. Típicamente, se mezclaron 4 g de grafito y 2,5 g de NaNO3, seguido de la adición de 100 ml de H2SO4 concentrado. La mezcla se sometió a ultrasonidos durante 30 minutos y se agitó durante un período de 4 h, manteniendo la temperatura a aproximadamente 5ºC usando un baño de hielo. Luego se añadieron gradualmente 12 g de KMnO4 manteniendo la temperatura de la mezcla por debajo de 15 ° C bajo agitación constante.
La mezcla se agitó durante 24 ha 35 ° C y la solución resultante se diluyó añadiendo 200 ml de agua. Para reducir el KMnO4 residual y el MnO2, la suspensión resultante se trató adicionalmente con 20 ml de solución de H2O2 al 30%. La mezcla obtenida se lavó sucesivamente con HCl y con agua destilada muchas veces hasta que el pH de la solución se volvió neutral. La mayor parte del agua se eliminó mediante secado en horno a 65 ° C durante 36 h.
Síntesis del nanohíbrido GO – Ag
El nanohíbrido GO-Ag se preparó mediante una estrategia simple de dos pasos. Brevemente, se dispersaron 20 mg de GO en 60 ml de PPh3 seguido de sonicación durante 1 h. Después de eso, la mezcla se calentó a reflujo bajo agitación vigorosa durante 24 horas a 200 ° C. Se preparó otra solución disolviendo 1,4 mg de AgNO3 en 20 ml de PPh3, y luego se añadió a la suspensión GO-PPh3. Después de la ultrasonicación durante 30 minutos, la mezcla se mantuvo durante 24 horas a 80 ° C bajo agitación continua en un sistema de reflujo hasta que el color de la suspensión se volvió negro-verde indicando la formación de partículas de Ag. El producto final se centrifugó a 4000 rpm durante 1 hora y se lavó con etanol diez veces. Finalmente, el nanohíbrido GO-Ag se secó al vacío a 80 ° C durante 24 h.
Actividad antimicrobiana
La actividad antimicrobiana de los nanohíbridos GO y GO – Ag se evaluó contra doce especies diferentes de gramnegativos (Escherichia coli, Serratia marcescens, Shigella sp, Salmonella sp, Serratia liquefaciens, Proteus sp, Enterobacter cloacae, Pseudomonas aeruginosa) y bacterias Gram-positivas. Usando el método de difusión en agar, las especies bacterianas se cultivaron en medio Luria-Bertani (LB) a 37 ° C durante 24 h. Las suspensiones de células bacterianas se diluyeron con agua fisiológica (0,1%) hasta que se alcanzó una concentración de 106 UFC / ml. Con un hisopo estéril, la suspensión bacteriana se sumergió en los inóculos y se rayó sobre la superficie de las placas de agar MH. Luego, se colocaron alícuotas de 25 µL de soluciones GO y GO-Ag (50 µg / ml) en la superficie de cada placa inoculada usando pinzas estériles y las placas se incubaron a 37 ° C durante 24 h. La formación de halos transparentes en la superficie del medio (zona de inhibición) indica el efecto antimicrobiano de las muestras a analizar.
Actividad antibacteriana dependiente del tiempo y de la concentración.
El método de la placa de extensión se utilizó para investigar el efecto del tiempo de contacto y la concentración sobre la actividad antimicrobiana del nanohíbrido GO-Ag contra Gram-negativas (Escherichia Coli). Para estudiar el efecto del tiempo de contacto y la concentración de nanohíbrido GO – Ag en la actividad microbiana, se realizó el mismo protocolo experimental con nanohíbrido GO – Ag, excepto que el tiempo de incubación fue de 4 h en lugar de 2 h para estudiar el efecto del tiempo de contacto. El efecto de la concentración sobre la actividad antimicrobiana. La pérdida de la viabilidad de las bacterias (%) se determinó por los recuentos de colonias de acuerdo con la siguiente fórmula:
![]() [1]
[1]
dónde:
LV: es la pérdida de viabilidad bacteriana
Nc: es el número de colonias en las placas de Petri de control
Nt: es el número de colonias en las placas de Petri tratadas.
El número de colonias en las placas de Petri de control y tratadas se contó en la misma proporción de dilución. Para observar la morfología de E. coli, las suspensiones celulares se pasaron a través de una membrana de baja porosidad (0.22 µm). Las partículas se retuvieron en la superficie del filtro y se fijaron con glutaraldehído y tetróxido de osmio, seguido de secado al aire. Finalmente, la morfología de las células de E. coli se examinó con el microscopio electrónico de barrido NEOSCOPE.
Dinámica Molecular y Farmacodinamia
En el aspecto cuantitativo se tabularon los datos con mayor afinidad a comportamiento antibacterial, considerando su dosis y el método utilizado. Los resultados serán utilizados para su posterior análisis espectral con el fin de desarrollar ecuaciones que el comportamiento antibacterial sobre la bacteria Escherichia Coli. Para ello se utiliza Dinámica Molecular, Farmacodinamia, software SIESTA.

Figura 1. Simulación de la molécula de grafeno en el Software.
Elaboración: Los autores.
Demostración experimental en Laboratorio
Mediante el aislamiento de la bacteria Escherichia Coli durante tres días utilizando el método de estiramiento, posterior se realizó antibiograma en incubadora a 36 °C durante dos días. Demostrando sensibilidad de la bacteria al óxido de grafeno.
RESULTADOS
Actividad antibacteriana de los nanohíbridos GO y GO-Ag con la bacteria E Coli (7) (8) (9) fueron muy prometedores; Se observó un círculo transparente que indica que hubo una inhibición en otras especies evaluadas como bacterias Gram-positivas y Gram-negativas. Esto refleja el gran efecto antibiótico del nanohíbrido GO-Ag, especialmente contra las bacterias Gram negativas, aunque se usó en una concentración baja. Estos resultados son contrarios a los obtenidos para otras bacterias (10) (11) (12).
Estos resultados también mostraron que no se observó ningún efecto inhibidor de GO contra la misma especie previamente probada. Esta resistencia podría atribuirse a la baja cantidad que no alcanzó la concentración inhibitoria mínima (MIC). A pesar del hecho de que muchos estudios han confirmado la alta toxicidad bacteriana de GO contra varias cepas bacterianas.
Esto se ajusta a los resultados de muchos estudios informados. Las teorías citadas aclaran el efecto de citotoxicidad de los nanotubos de carbono contra las células bacterianas. Según esta teoría, el mecanismo de acción se produce en tres pasos: adhesión de células bacterianas en nanoesferas de grafeno, perforación física de la membrana celular, en otras palabras, estrés de membrana y, en tercer lugar, la aparición de estrés oxidativo (13) (14) (15) (16).
El efecto del segundo paso depende del tipo de especie (Gram-positivo o Gramnegativo), mientras que el tercer paso está fuertemente relacionado con la estructura electrónica del material, cuanto más material es un buen controlador actual, mayor es su efectividad antimicrobiana es fuerte, esto es apropiado para la situación estudiada, donde el proceso de oxidación del grafito conduce a una disminución en el nivel de transferencia de electricidad del GO producido (17), lo que reduce su efectividad biológica, especialmente si se usa con baja concentración, lo que explica su inercia biológica y su incapacidad para detener la proliferación de bacterias durante el primer experimento (18) (19) (20).
En consecuencia, este contacto provoca un aumento en el efecto del estrés oxidativo, así como la perforación mecánica de la pared celular por los bordes agudos de GO, especialmente para las especies Gramnegativas cuya pared celular está formada por una sola capa delgada de peptidoglicano.
Sin embargo, la E. coli toma una forma inusual e irregular que confirma la perforación y la ruptura de la pared celular, que es su función más importante que garantiza la integridad de las bacterias y mantiene su forma (21) (22) (23). Esto refleja también los resultados encontrados en los primeros experimentos donde la mayoría de las especies que exhiben una sensibilidad contra el nanohíbrido GO-Ag son los de las bacterias Gram-negativas. Estos resultados confirman la proporcionalidad entre el aumento del tiempo de contacto y la concentración con el efecto antibacteriano. La dinámica de las partículas puede ser demostrada aplicando la integración de la segunda ley de Newton en espacios limitados, valores discretos los cuales al ser sumados y analizados como el comportamiento de las vibraciones del óxido de grafeno.
Analíticamente se considera que la eficacia es de mayor importancia a la potencia dato que ayuda a utilizar termodinámica estadística con el fin de obtener ecuaciones que pueden predecir el movimiento de los átomos de la membrana de una bacteria. Este estudio omite el análisis experimental para un número determinado de bacterias como, por ejemplo, el helicobacter pylori (24) (25) (26).
Los datos obtenidos por experimentación al interactuar Oxido de grafeno reducido con Escherichia Coli, ayuda a describir el comportamiento del grafeno en Helicobacter Pylori utilizando el método de Dinámica Molecular y simulaciones de membrana. Donde a cada complejo BACTERIA-OXIDO DE GRAFENO REDUCIDO se lo considera como un paquete de información. Sus ecuaciones se describen de la siguiente forma:
![]() [2]
[2]
Donde, la fuerza de los átomos que constituyen la membrana de la bacteria depende de la composición y campo de fuerza de la estructura completa. Al integrar la ecuación se obtiene
![]()
![]() [3]
[3]

Esta ecuación describe el comportamiento de la membrana de una bacteria en un tiempo de 2 ns, considerando los ángulos de distribución de toda la estructura de la membrana de la bacteria. Se considera que su integración en 2 ns es suficiente para considerar un muestreo de las vibraciones más pequeñas de los átomos pesados y ligeros de la estructura.
Resultados mediante experimentación en el Laboratorio
El óxido de grafeno como resultado al antibiograma genera un halo de inhibición específico y tangible debido al tamaño de la molécula y su polaridad (27) (28) (29) (30). Al compararlo con otros antibióticos se observó que su peso molecular atribuye que el óxido de grafeno tendrá mayor capacidad de inhibición.
Figura 2. Procedimiento de antibiograma con oxido degrafeno.
Elaboración: Los autores.
CONCLUSIONES
Se investigó la actividad antibacteriana del nanohíbrido GO-Ag contra los dos tipos de cepas de bacterias, Gram-positivas y Gram-negativas, y se obtuvieron resultados prometedores. Sin embargo, los efectos contradictorios observados con respecto a la sensibilidad del mismo tipo de bacterias Gram contra el nanohíbrido GO-Ag nos lleva a intensificar la investigación en esta vasta y compleja área para lograr una comprensión clara y precisa del mecanismo antibacteriano de este nanohíbrido. Además, queda otra pregunta si esta propiedad está reservada cuando se incorpora este nanohíbrido en diferentes matrices, que exactamente se investigará en futuros estudios.
El nanohíbrido GO – Ag se sintetizó con éxito mediante una conveniente estrategia permitiendo realizar los cálculos cuanto-mecánicos de la interacción del H2 en grafeno puro utilizando y el software SIESTA y los modelos moleculares del óxido de grafeno.
El estudio de termodinámica clásica y experimentación de la interacción bacterias gram- con óxido de grafeno fueron necesarios para poder desarrollar una ecuación matemática que simplifique la parte experimental del proceso de confirmación bactericida.
El óxido de grafeno es un material prometedor para aplicaciones biomédicas ya que al funcionalizarse puede dirigirse a las células donde debe ejercer su acción, además de eliminarse de manera rápida en el organismo. Las propiedades biológicas de los derivados de grafeno aún no son examinaron a fondo, por lo tanto, su citotoxicidad debe estudiarse en profundidad.
El óxido de grafeno genera mejores resultados al tener un disco de sensibilidad de bacteria con buen proceso de aislamiento. Para mejores resultados se utilizará a futuro, diferentes métodos.
CONFLICTO DE INTERÉS
Los autores declaran que no tienen conflicto de interés en la publicación del artículo.
FINANCIAMIENTO
Autofinanciado.
AGRADECIMIENTO
A la Universidad Regional Autónoma de los Andes, por apoyar el desarrollo de la investigación.
REFERENCIAS
- Daniyal M, Liu B, Wang W. Comprehensive Review on Graphene Oxide for Use in Drug Delivery System. Curr Med Chem. 2020;27(22):3665-3685. doi: 10.2174/13816128256661902011296290
- Manousi N, Rosenberg E, Deliyanni EA, Zachariadis GA. Sample Preparation Using Graphene-Oxide-Derived Nanomaterials for the Extraction of Metals. Molecules. 2020;25(10):2411. doi:10.3390/molecules25102411
- Nichols F, Chen S. Graphene Oxide Quantum Dot-Based Functional Nanomaterials for Effective Antimicrobial Applications. Chem Rec. 2020;20(12):1505-1515. doi:10.1002/tcr.202000090
- Yildiz G, Bolton-Warberg M, Awaja F. Graphene and graphene oxide for bio-sensing: General properties and the effects of graphene ripples. Acta Biomater. 2021;131:62-79. doi:10.1016/j.actbio.2021.06.047
- Raslan A, Saenz Del Burgo L, Ciriza J, Pedraz JL. Graphene oxide and reduced graphene oxide-based scaffolds in regenerative medicine. Int J Pharm. 2020;580:119226. doi:10.1016/j.ijpharm.2020.119226
- Aguila IP, Velázquez-López L, Goycochea-Robles MAV, Angulo-Angulo F, Peña JE. Multimedia education to support management of type 2 diabetes patients. A quasi-experimental study [La educación multimedia como apoyo en el manejo de pacientes con diabetes tipo 2. Estudio cuasi experimental]. Cir Cir. 2018;86(5):404-411. doi:10.24875/CIRU.18000119
- Jang J, Hur HG, Sadowsky MJ, Byappanahalli MN, Yan T, Ishii S. Environmental Escherichia coli: ecology and public health implications-a review. J Appl Microbiol. 2017;123(3):570-581. doi:10.1111/jam.13468
- Paitan Y. Current Trends in Antimicrobial Resistance of Escherichia coli. Curr Top Microbiol Immunol. 2018;416:181-211. doi:10.1007/82_2018_110
- Mazzariol A, Bazaj A, Cornaglia G. Multi-drug-resistant Gram-negative bacteria causing urinary tract infections: a review. J Chemother. 2017;29(sup1):2-9. doi:10.1080/1120009X.2017.1380395
- Wassenaar TM. E. coli and colorectal cancer: a complex relationship that deserves a critical mindset. Crit Rev Microbiol. 2018;44(5):619-632. doi:10.1080/1040841X.2018.1481013
- Letuta UG, Berdinskiy VL. Biological effects of static magnetic fields and zinc isotopes on E. coli bacteria. Bioelectromagnetics. 2019;40(1):62-73. doi:10.1002/bem.22162
- Negrete A, Shiloach J. Improving E. coli growth performance by manipulating small RNA expression. Microb Cell Fact. 2017;16(1):198. Published 2017 Nov 14. doi:10.1186/s12934-017-0810-x
- Raad SH, Atlasbaf Z. Broadband/multiband absorption through surface plasmon engineering in graphene-wrapped nanospheres. Appl Opt. 2020;59(28):8909-8917. doi:10.1364/AO.400775
- Brown AT, Lin J, Vizuet JP, Thomas MC, Balkus KJ. Graphene-like Carbon from Calcium Hydroxide. ACS Omega. 2021;6(46):31066-31076. Published 2021 Nov 10. doi:10.1021/acsomega.1c04305
- Raja Jamaluddin RZA, Tan LL, Chong KF, Heng LY. An electrochemical DNA biosensor fabricated from graphene decorated with graphitic nanospheres. Nanotechnology. 2020;31(48):485501. doi:10.1088/1361-6528/abab2e
- Wang ZZ, Wu PF, Yue HY, et al. Electrochemical Determination of Levodopa Using Zinc Sulfide Nanospheres-Reduced Graphene Oxide. J Nanosci Nanotechnol. 2021;21(11):5666-5672. doi:10.1166/jnn.2021.19486
- He J, Jiang L, Chen Y, Luo Z, Yan Z, Wang J. Facile direct synthesis of graphene-wrapped ZnO nanospheres from cyanobacterial cells. Chem Commun (Camb). 2019;55(76):11410-11413. doi:10.1039/c9cc04951g
- Atchudan R, Edison TNJI, Perumal S, Karthikeyan D, Lee YR. Facile synthesis of zinc oxide nanoparticles decorated graphene oxide composite via simple solvothermal route and their photocatalytic activity on methylene blue degradation. J Photochem Photobiol B. 2016;162:500-510. doi:10.1016/j.jphotobiol.2016.07.019
- Peng Y, Ye G, Du Y, et al. Fe3O4 hollow nanospheres on graphene oxide as an efficient heterogeneous photo-Fenton catalyst for the advanced treatment of biotreated papermaking effluent. Environ Sci Pollut Res Int. 2021;28(29):39199-39209. doi:10.1007/s11356-021-13458-9
- Kang W, Cui Y, Qin L, et al. A novel robust adsorbent for efficient oil/water separation: Magnetic carbon nanospheres/graphene composite aerogel. J Hazard Mater. 2020;392:122499. doi:10.1016/j.jhazmat.2020.122499
- Blount ZD. The unexhausted potential of E. coli. Elife. 2015;4:e05826. Published 2015 Mar 25. doi:10.7554/eLife.05826
- Leimbach A, Hacker J, Dobrindt U. E. coli as an all-rounder: the thin line between commensalism and pathogenicity. Curr Top Microbiol Immunol. 2013;358:3-32. doi:10.1007/82_2012_303
- Green R, Rogers EJ. Transformation of chemically competent E. coli. Methods Enzymol. 2013;529:329-336. doi:10.1016/B978-0-12-418687-3.00028-8
- Crowe SE. Helicobacter pylori Infection. N Engl J Med. 2019;380(12):1158-1165. doi:10.1056/NEJMcp1710945
- Du LJ, Chen BR, Kim JJ, Kim S, Shen JH, Dai N. Helicobacter pylori eradication therapy for functional dyspepsia: Systematic review and meta-analysis. World J Gastroenterol. 2016;22(12):3486-3495. doi:10.3748/wjg.v22.i12.3486
- Fischbach W, Malfertheiner P. Helicobacter Pylori Infection. Dtsch Arztebl Int. 2018;115(25):429-436. doi:10.3238/arztebl.2018.0429
- Grant JJ, Pillai SC, Hehir S, McAfee M, Breen A. Biomedical Applications of Electrospun Graphene Oxide. ACS Biomater Sci Eng. 2021;7(4):1278-1301. doi:10.1021/acsbiomaterials.0c01663
- Umekar MS, Bhusari GS, Potbhare AK, et al. Bioinspired Reduced Graphene Oxide Based Nanohybrids for Photocatalysis and Antibacterial Applications. Curr Pharm Biotechnol. 2021;22(13):1759-1781. doi:10.2174/1389201022666201231115826
- Rai VK, Mahata S, Kashyap H, Singh M, Rai A. Bio-reduction of Graphene Oxide: Catalytic Applications of (Reduced) GO in Organic Synthesis. Curr Org Synth. 2020;17(3):164-191. doi:10.2174/1570179417666200115110403
- Palmieri V, Perini G, De Spirito M, Papi M. Graphene oxide touches blood: in vivo interactions of bio-coronated 2D materials. Nanoscale Horiz. 2019;4(2):273-290. doi:10.1039/c8nh00318a
2021 por los autores. Este artículo es de acceso abierto y distribuido según los términos y condiciones de la licencia Creative Commons Atribución-NoComercial-CompartirIgual 4.0 Internacional (CC BY-NC-SA 4.0) (https://creativecommons.org/licenses/by-nc-sa/4.0/).